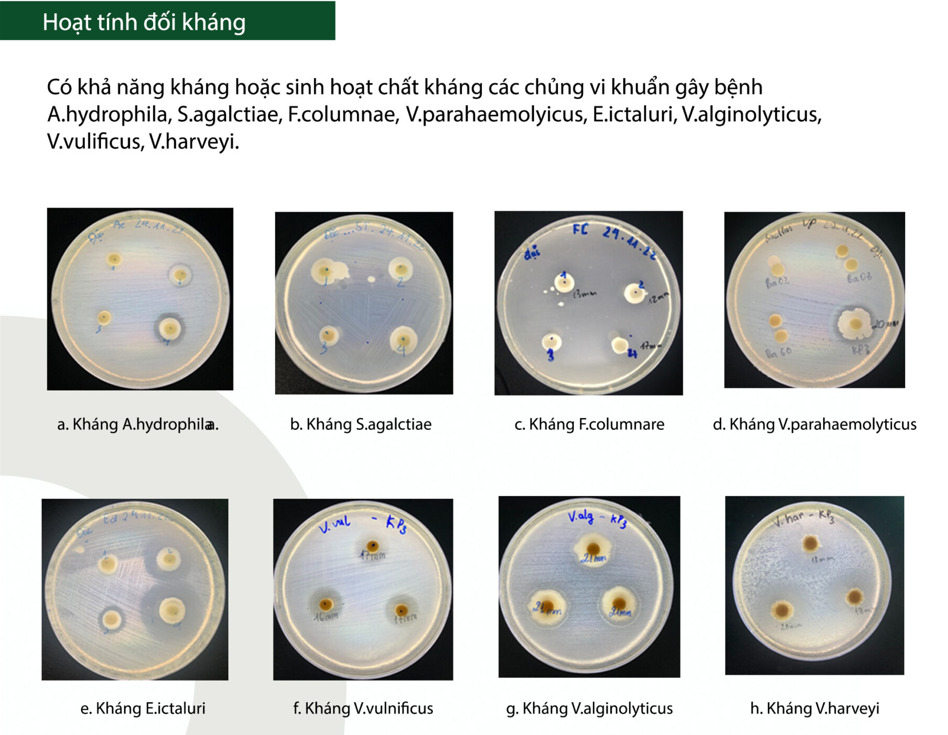
Bacillus amyloliquefaciens

Trong sản xuất chế phẩm sinh học quy mô công nghiệp, chủng giống quyết định trực tiếp đến hiệu quả sản phẩm cuối, độ ổn định lô hàng và uy tín thương hiệu. Không phải mọi chủng Bacillus amyloliquefaciens đều phù hợp cho điều kiện sản xuất và ứng dụng tại Việt Nam.
Bacillus amyloliquefaciens KP3 – chủng vi sinh bản địa do Công ty TNHH Bio-Floc phân lập, bảo quản và sản xuất – được phát triển chuyên biệt nhằm đáp ứng yêu cầu khắt khe của các nhà máy và doanh nghiệp sản xuất chế phẩm sinh học thủy sản, thú y và cây trồng.
Dưới đây là những điểm khác biệt cốt lõi giúp KP3 trở thành nguyên liệu đầu vào chiến lược cho sản xuất công nghiệp.

Contents
- 1. Chủng vi sinh bản địa – tối ưu cho điều kiện sản xuất và ứng dụng thực tế tại Việt Nam
- 2. Độ ổn định nguyên liệu vượt trội – yếu tố then chốt cho sản xuất công nghiệp
- 3. Hoạt tính sinh học mạnh – tăng hiệu quả sản phẩm cuối
- 4. Khả năng đối kháng vi khuẩn gây bệnh – đã được kiểm chứng
- 5. Chủng chiến lược cho doanh nghiệp sản xuất chế phẩm sinh học
1. Chủng vi sinh bản địa – tối ưu cho điều kiện sản xuất và ứng dụng thực tế tại Việt Nam
Khác với các chủng nhập khẩu, Bacillus amyloliquefaciens KP3 được phân lập trực tiếp từ bùn đáy ao nuôi tôm tại Việt Nam. Đây là yếu tố nền tảng giúp chủng:
- Thích nghi tốt với môi trường nhiệt đới nóng ẩm
- Phù hợp với hệ sinh thái thủy sản nước lợ đặc thù
- Hoạt động ổn định khi đưa trực tiếp vào ao nuôi hoặc quy trình sản xuất chế phẩm
Dải thích nghi sinh học rộng của KP3:
- pH hoạt động: 5 – 10
- Nhiệt độ sinh trưởng tối ưu: 25 – 35°C
- Khả năng chịu mặn: 0 – 50‰
- Khả năng chịu acid: ≥ 3 giờ ở pH 2,0

Đối với nhà máy sản xuất, điều này đồng nghĩa với:
- Ít rủi ro suy giảm hoạt lực sau khi ứng dụng
- Rút ngắn thời gian thích nghi của sản phẩm ngoài thực địa
- Hiệu quả thể hiện nhanh và ổn định hơn so với chủng nhập khẩu
2. Độ ổn định nguyên liệu vượt trội – yếu tố then chốt cho sản xuất công nghiệp
Trong sản xuất chế phẩm sinh học, độ ổn định của nguyên liệu là tiêu chí quan trọng hàng đầu. KP3 được Bio-Floc sản xuất ở 100% dạng bào tử, mang lại nhiều lợi thế vượt trội cho doanh nghiệp.

Hệ thống sản xuất hiện đại tại Bio-Floc:
- Lên men bằng hệ thống tự động khép kín
- Cô đặc bằng công nghệ lọc tiếp tuyến (TFF)
- Sấy bằng công nghệ phun sấy tầng sôi
Công nghệ sấy tầng sôi – xử lý ở nhiệt độ thấp – giúp:
- Bảo toàn cấu trúc bào tử
- Tránh phá hủy tế bào vi sinh
- Duy trì hoạt tính sinh học cao
Lợi ích trực tiếp cho nhà máy:
- Nguyên liệu ổn định trong bảo quản và vận chuyển
- Không giảm CFU trong quá trình lưu kho
- Dễ phối trộn vào nhiều công thức sản phẩm
- Đảm bảo chất lượng lô hàng đồng nhất, giảm hao hụt sản xuất
3. Hoạt tính sinh học mạnh – tăng hiệu quả sản phẩm cuối
KP3 nổi bật nhờ hệ enzyme ngoại bào đa dạng, là nền tảng để gia tăng giá trị cho các dòng chế phẩm xử lý môi trường và bổ sung thức ăn:
- Amylase: phân giải tinh bột
- Cellulase: phân hủy cellulose và chất xơ
- Protease: phân giải protein

Nhờ vậy, sản phẩm sử dụng KP3 giúp:
- Phân hủy nhanh chất hữu cơ trong ao nuôi
- Giảm tích tụ bùn đáy
- Tăng hiệu quả tiêu hóa cho vật nuôi
- Nâng cao hiệu quả sinh học so với các chủng hoạt tính thấp
Đối với doanh nghiệp, đây là yếu tố giúp sản phẩm có hiệu quả rõ rệt ngoài thực tế, tăng khả năng cạnh tranh trên thị trường.
4. Khả năng đối kháng vi khuẩn gây bệnh – đã được kiểm chứng
Bên cạnh đó, Bacillus amyloliquefaciens KP3 thể hiện khả năng đối kháng mạnh với nhiều chủng vi khuẩn gây bệnh nguy hiểm trên tôm và cá.
Tại Công ty TNHH Bio-Floc, khả năng kháng khuẩn của chủng Bacillus amyloliquefaciens KP3 được đánh giá thông qua các thí nghiệm in vitro, và kết quả thu được như sau:
- Aeromonas hydrophila – tác nhân gây nhiễm khuẩn đường ruột, xuất huyết và hoại tử mô mềm trên tôm, đồng thời gây bệnh xuất huyết trên cá: vòng kháng khuẩn đạt 15,5 mm
- Streptococcus agalactiae – tác nhân gây bệnh liên cầu khuẩn trên cá: vòng kháng khuẩn đạt 11,5 mm
- Flavobacterium columnare – tác nhân gây bệnh trắng da, bạc mang, trắng đuôi trên cá nước ngọt: vòng kháng khuẩn đạt 16,5 mm
- Vibrio parahaemolyticus – tác nhân gây bệnh gan tụy cấp tính trên tôm: vòng kháng khuẩn đạt 17 mm
- Edwardsiella ictaluri – tác nhân gây bệnh gan thận mủ trên cá da trơn: vòng kháng khuẩn đạt 16,5 mm
- Vibrio alginolyticus – tác nhân gây bệnh đỏ dọc thân trên ấu trùng tôm sú: vòng kháng khuẩn đạt 21 mm
- Vibrio vulnificus – tác nhân gây bệnh xuất huyết trên cá: vòng kháng khuẩn đạt 16,7 mm
- Vibrio harveyi – tác nhân gây bệnh phát sáng trên tôm: vòng kháng khuẩn đạt 19 mm
5. Chủng chiến lược cho doanh nghiệp sản xuất chế phẩm sinh học
Với nguồn gốc bản địa, độ ổn định cao và hoạt lực mạnh, Bacillus amyloliquefaciens KP3 đáp ứng tốt các yêu cầu của:
- Nhà máy sản xuất chế phẩm vi sinh thủy sản
- Doanh nghiệp sản xuất phụ gia thức ăn chăn nuôi
- Đơn vị nghiên cứu và R&D công thức vi sinh
- Nhà máy OEM / gia công chế phẩm sinh học

Bio-Floc không chỉ cung cấp nguyên liệu KP3 mà còn:
- Hỗ trợ kỹ thuật
- Đồng hành R&D
- Đảm bảo chất lượng và nguồn cung ổn định lâu dài
Trong bối cảnh thị trường chế phẩm sinh học ngày càng cạnh tranh, lựa chọn đúng chủng vi sinh chính là lợi thế chiến lược. Bacillus amyloliquefaciens KP3 – chủng bản địa do Bio-Floc nghiên cứu và phát triển – mang lại hiệu quả sinh học cao, độ ổn định vượt trội và giá trị ứng dụng bền vững cho doanh nghiệp sản xuất.
Bio-Floc – Đối tác vi sinh bản địa cho ngành sản xuất chế phẩm sinh học Việt Nam.
Tìm hiểu bộ nguyên liệu vi sinh bản địa cho nhà máy sản xuất đạt chuẩn Quốc tế

